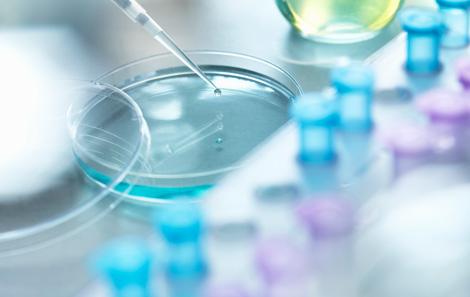

Bone Marrow Transplant Procedure
Make an Appointment
During a bone marrow transplant procedure, donor stem cells get put into your body. These healthy stem cells will begin creating new blood cells.
This procedure - a stem cell transplant - takes less than a day. But preparing and recovering from a bone marrow transplant involves several steps.
The First Step of Bone Marrow Transplant
This new patient evaluation could take a few hours. We'll have to find out if you qualify for the procedure. We also need to decide what type of transplant makes sense for you.
You’ll meet with several people, including:
- Your stem cell transplant doctor
- A transplant nurse coordinator
- Our social worker, to go over housing and disability paperwork
- Our financial coordinator, to review insurance coverage
In this session, we'll:
- Review your records
- Discuss donor options
- Recommend treatments
- Answer your questions
Do You Have a Possible Donor?
If you have a family member or friend interested in being a stem cell donor, we’ll explain donor testing.
Prepping for the Bone Marrow Transplant Procedure
Once we have a donor, you'll have another appointment at the clinic. You’ll get a preview of what to expect. We'll help you get ready for transplant and talk about your medications and upcoming stay. We might also need to test your heart and lungs.
At this appointment, you’ll have the chance to go over details with your:
- Nurse coordinator
- Doctor
- Social worker
- Pharmacist
- Financial coordinator
- Nutritionist
Preparing Your Body for the Transplant
To ready your body for a safe procedure, you’ll need:
- Radiation and/or chemotherapy to kill cancer cells and ready your body for fresh stem cells
- Tests to make sure your tissue and the donor’s match
- Medicine to suppress your immune system, so your body doesn’t reject the donor cells
We’ll also make sure to test the donor’s blood for disease.
BMT Infusion
The stem cell transplant procedure can take several hours. You shouldn’t feel any pain. If you feel sick, we have medication that can help. During infusion, we'll help you stay warm and relaxed.
Get the details on infusion therapy.
After Your Stem Cell Transplant
As your new stem cells get to work, you'll need to stay healthy. Learn about bone marrow transplant recovery.
Cancer & COVID-19
For your safety and protection, we're testing everyone for COVID-19 72 hours before treatment. If you have COVID, we'll work with you on next steps.
Visit the Stem Cell Transplant Clinic
Stem cell transplant treats a number of cancers and blood disorders. Survival rates continue to increase. Let's find out if stem cell transplant could work for you.
Visit the Stem Cell Transplant Clinic